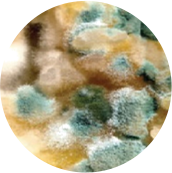

mầm lúa mì
( Wheat Germ )
 Mầm lúa mì là phần phôi của lúa mì, giàu vitamin và lipid, và là phần nảy mầm.
Mầm lúa mì là phần phôi của lúa mì, giàu vitamin và lipid, và là phần nảy mầm. Để sử dụng khoảng 60,000 tấn chất thải mầm lúa mì trong nước và khoảng 20 triệu tấn trên toàn cầu, chúng tôi đang tiến hành nghiên cứu và phát triển liên tục. Bằng cách sử dụng chiết xuất mầm lúa mì với hoạt tính kháng khuẩn tuyệt vời (được cấp phép và phát triển chung bởi Đại học Hannam), chúng tôi đã phát triển các vật liệu kháng khuẩn với nhiều chức năng như kháng khuẩn, chống oxy hóa, và chống viêm, và đã phát triển các thành phần mỹ phẩm cơ bản và thực phẩm chức năng sức khỏe dựa trên chiết xuất mầm lúa mì.


Eugene Biotech hướng đến việc xem xét lại ý nghĩa thực sự của sức khỏe và tích cực tham gia vào việc cải thiện các vấn đề ô nhiễm môi trường. Để sử dụng khoảng 60,000 tấn chất thải mầm lúa mì trong nước và toàn cầu hàng năm, Eugene Biotech đang tiến hành nghiên cứu và phát triển liên tục.

-
Trong quá trình chế biến bột mì

Tiêu thụ bột mì trong nước ở Hàn Quốc là 1.92 triệu tấn.
Tiêu thụ bột mì toàn cầu là 730 triệu tấn. -
Những lý do khiến giá các sản phẩm bột mì giảm
Giảm độ ổn định lưu trữ của bột mì
Vấn đề với sự hư hỏng trong quá trình lưu trữ
Phát triển vị đắng -
Mầm lúa mì và cám (cám lúa mì) bị tách ra và bỏ đi

Chất thải mầm lúa mì trong nước là 60,000 tấn
Chất thải mầm lúa mì toàn cầu là 20 triệu tấn
Bằng cách sử dụng chiết xuất mầm lúa mì với hoạt tính kháng khuẩn tuyệt vời (thông qua chuyển giao công nghệ và phát triển chung với Đại học Hannam), chúng tôi đã phát triển các vật liệu kháng khuẩn với nhiều chức năng như kháng khuẩn, chống oxy hóa, và chống viêm. Ngoài ra, chúng tôi đã phát triển các thành phần mỹ phẩm cơ bản và thực phẩm chức năng sức khỏe dựa trên chiết xuất mầm lúa mì.
Nhiều cơ hội kinh doanh đa dạng có thể được khám phá bằng cách sử dụng các thành phần chức năng cao hiện có trong các sản phẩm phụ của bột mì bán lẻ như mầm lúa mì và cám.

- 1. Phát triển các vật liệu kháng khuẩn tự nhiên sử dụng chiết xuất mầm lúa mì với hoạt tính kháng khuẩn tuyệt vời.
- 2. Các vật liệu kháng khuẩn tự nhiên có độ ổn định nhiệt và pH tuyệt vời.
- 3. Các vật liệu kháng khuẩn tự nhiên có thể được áp dụng cho nhiều sản phẩm như thực phẩm, thức ăn chăn nuôi, mỹ phẩm và khăn ướt.
- 4. Xác nhận hiệu quả chống viêm và chống oxy hóa (có thể mở rộng sang nhiều lĩnh vực khác nhau thông qua nghiên cứu và phát triển thêm trong tương lai).







